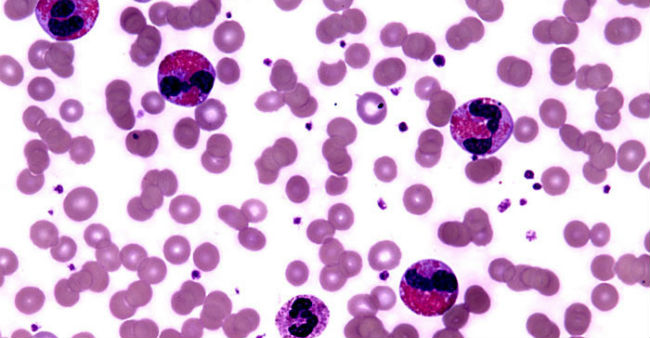

Você notou um nível de eosinófilos alto no seu último exame de sangue e ficou com uma pulguinha atrás da orelha?
Quando vemos alguma alteração em exames médicos, é normal ficarmos preocupados. Por isso é importante entender o que cada informação ali presente significa.
Então, vamos nos aprofundar um pouco sobre um glóbulo branco em particular: os eosinófilos. Eles são um tipo de célula que compõem o sistema imunológico, e seus níveis aumentam quando há algum processo inflamatório ou alérgico.
Vamos então entender um pouco mais sobre o que essa célula faz e o que significa estar com o nível de eosinófilos alto ou baixo demais.
- Veja também: Leucócitos altos ou baixos demais – O que significa?
O que são eosinófilos?
As células do sangue são divididas em glóbulos vermelhos e glóbulos brancos, também chamados de leucócitos. Os glóbulos brancos fazem parte do sistema imunológico e existem cinco tipos principais:
- Neutrófilos
- Basófilos
- Linfócitos
- Monócitos
- Eosinófilos
Os eosinófilos são formados na medula óssea: eles têm origem a partir da diferenciação de uma célula produzida na medula óssea, conhecida como mieloblasto.
Em comparação com as outras células de defesa do organismo, os eosinófilos circulam em uma concentração mais baixa no corpo.

Quais os valores normais de eosinófilos?
O nível de eosinófilos no sangue de uma pessoa é medido por meio do leucograma, a parte do hemograma que avalia as células brancas do organismo.
Os valores considerados normais de eosinófilos no sangue são 20 a 500 células por microlitro (µL) de sangue, para valores absolutos ou a contagem total de eosinófilos no sangue, ou 1 a 6%, para valores relativos ou a porcentagem de eosinófilos em relação às outras células analisadas no leucograma.
No entanto, os valores de referência podem ter algumas alterações conforme o laboratório responsável pela realização do exame.
Um nível de eosinófilos alto ou baixo deve sempre ser avaliado pelo médico, que é quem deve fechar o diagnóstico e indicar o tratamento necessário.
Na sua análise, o médico não vai levar em consideração apenas a taxa de eosinófilos, mas também os outros resultados do hemograma e de demais exames que ele solicitar, assim como a história clínica do paciente.
Da mesma forma, o paciente deve relatar ao médico os sintomas que está experimentando. Afinal, esses sintomas podem ser parte importante de toda a avaliação que o profissional de saúde realiza antes de dar um diagnóstico.
O que significa o nível de eosinófilos alto?
A eosinofilia, que é como chamamos o excesso de eosinófilos no sangue, não é um problema de saúde em si, mas pode ser um sinal associado a algumas doenças.
Apesar de ser algo comum, ela deve ser investigada, principalmente quando os valores estão muito altos ou quando o nível de eosinófilos alto é um resultado recorrente.
Na maioria das vezes a eosinofilia está relacionada a:
- Reação ao uso de medicamentos, como AAS, antibióticos, anti-hipertensivos ou triptofano
- Doenças inflamatórias da pele, como dermatites
- Doença inflamatória intestinal
- Doenças hematológicas
- Infecção por vírus, fungos ou bactérias
- Infecções parasitárias
- Doenças autoimunes
- Tumores
- Reações alérgicas
Existem também os casos de hipereosinofilia, que ocorrem quando o nível de eosinófilos é alto demais no sangue, ultrapassando 10 mil células/µL. Isso é mais comum em doenças autoimunes e genéticas, como a síndrome hipereosinofílica.
Os níveis elevados de eosinófilos podem ocorrer no sangue e também em outros tecidos do corpo, em locais com a presença de infecção ou inflamação.
A eosinofilia em outras partes do corpo pode ser identificada através de amostras colhidas durante alguns procedimentos, ou mesmo em amostras de fluidos corporais, como o muco dos tecidos nasais.
O que significa eosinófilos baixos?
Em alguns casos, o número de eosinófilos também pode estar abaixo do normal, algo que recebe o nome de eosinopenia.
Essa diminuição pode significar diferentes problemas de saúde, sendo possível que a pessoa esteja com a imunidade comprometida por conta de doenças ou do uso de remédios que alteram a função do sistema imunológico, como os corticoides.
A eosinopenia pode estar presente quando há infecções bacterianas agudas, como pneumonia ou meningite, que geralmente aumentam os níveis de outros tipos de células de defesa, como os neutrófilos, o que pode reduzir a contagem absoluta ou relativa dos eosinófilos.
Uma baixa no nível de eosinófilos também pode estar relacionada à anemia perniciosa, queimaduras, síndrome de Cushing, convulsões ou pós-cirúrgico.
Entretanto, o mais comum é que a contagem de eosinófilos abaixo do normal seja algo sem significado clínico e que se resolve espontaneamente.
Cuidados e dicas
Normalmente, o nível alterado de eosinófilos só é identificado quando o médico solicita um exame de sangue, pois não é algo que causa sintomas. Desta forma, boa parte dos casos de eosinofilia são encontrados por acaso em exames de rotina.
Assim que o problema for identificado, antes de se desesperar, é necessário que se busque a orientação de um médico para que se possa fazer uma investigação das possíveis causas.
Fontes e referências adicionais
- Eosinophils from Physiology to Disease: A Comprehensive Review, Biomed Res Int. 2018; 2018: 9095275.
- Eosinophilic esophagitis: a review, JAMA 326: 1310–1318, 2021.
- Eosinophilia, Mayo Clinic
- Eosinophilia, Cleveland Clinic



Sempre tive eosinófilolos em 1 e recentemente deu 6…estou tendo há algum tempo sensaçao de secura no esofago(parece que é no pulmão). Não tenho gripes, nem resfriados e nem tosse( a últimas tosse há 25 anos). Nunca tive asma..do nada apareceu uma tosse muito seca, ontem, ao deitar e tive alguns episódios de tosse à noite. O exame de.sangue foi há 15 dias…
Tenho síndrome hipereosinofílico idiopático. Tomo lepicortinolo ininterruptamente há 10 anos. já subiram para 6700, recentemente em outubro subiram para 3480, subi a dosagem para 20 mg, já desceram mas agora estou a fazer 10 mg e subiram novamente para 960. Nos dois últimos anos não estou a conseguir estabilizar nos 5mg. É uma situação rara e como tal difícil de controlar
Meu exame de sangue acusou Eosinofilos 8% E 608/mm3 e grave
Boa tarde me chamo claudia
Fiz um hemograma a unica coisa que constou alto foi eosinofilos que deu 821, li bastante arquivos e relatos … estou um pouco preocupada oque pode ser sera ?
Minha filha fez exame de sangue de eosinofilos 4% e do meu sobrinho de 12%. Tou preocupa. O que pode ser
Olá boa meu neto de 4 anos estava tendo dores na barriga vômito e desenvolvimento exames de sangue e de eosinofilos 10.1 o médico falou e parasitas intestinais passou anota 3 dias
Bom dia, meu nome é Henrique, no final de 2016 comecei a perder o apetite e por consequência, peso…total de -23kg em 2 meses e meio. A princípio, o médico do posto de saúde disse que era depressão, mas eu sabia que não era. Foi quando comecei sentir dores fortes no estômago e paguei uma consulta com um profissional em sistema digestivo. Pediu vários exames: ultrassonografia, raio x, testes de HIV e hepatite, mas foi ao ver no resultado do meu hemograma que os eosinófilos estavam em 31.000…isso mesmo (trinta e um mil) por microlitro de sangue. Fui imediatamente mandado para o Hospital das Clínicas, no Campus da USP de Ribeirão Preto, onde fiquei internado por 12 dias, fazendo exames de todos os tipos…descartando varias hipóteses, e , por enquanto, faço ainda tratamento e sou diagnosticado com Síndrome Hipereosinofilica. Recuperei o meu peso e as forças, mas só mantenho os eosinófilos a baixo de 2000, tomando predinisona. Tenho muita história pra contar sobre isso…
Devido a esse aumento de eosinófilos, tive miocárdite, já quase recuperada, entre outras complicações e inúmeros sintomas muito loucos.
Se houver interesse, a gente conversa mais…é só entrar em contato.
Boa tarde Henrique, me chamo Aldo, estou com os Eosinófilos em 672, estou me coçando muito e alguns carocinhos apareceram no meu corpo que coço bastante, alguns já se tornarem feridas. O que você me diz sobre essa situação.
Acabei de pegar o resultado do meu exame de sangue e o Eosinofilos está em 680/m3. Irei passar no médico na segunda-feira. Estou com os mesmos sintomas, coceira na região do tronco. O que seu médico receitou à você?
Eu ja tomei fenergan, dexametazona injetavel, os.sintomas diminuem, mas infelizmente voltam, é um desespero com essa coceira, vou procurar um alergista, esta me incomodando.muito. aparecem jns carocos que.vao e voltam vermelhos… vc tomou algo, como.esta se sentindo?
Aldo, você melhorou destes sintomas? Também estou passando por isso. Eosinofilos altos 9,1%. Alergias, coceira na pele. Só melhoro temporariamente quando tomo Dexametasona 4mg comprimido.
MEU FILHO ESTA COM CERCA DE 10.000 EOSINÓFILOS. REALIZOU VÁRIOS EXAMES E NÃO APARECE NENHUM PROBLEMA. A MEDICA ACHA QUE E LEUCEMIA OU DOENÇA EOSINOFILA REATIVA. ESTOU DESESPERADA. PEDIU UM IMUNOFENOTIPAGEM DO SANGUE PERIFERICO.
Também fiz um exame de sangue e deu 614mm de eosinófilos
Vou ao médico na terça feira
Estou preocupada
Mas não tenho sintoma nenhum
O que vc pode me dizer
Boa noite, o meu nome é Rosa, tenho o mesmo problema (sindrome hipereosinofílica idiopática). Já estive hospitalizada, em 2011, com 1m60 de altura estava com 40kg, estavam a destruir o meu colon, tiroide, e exófago, entre outros problemas também me afetou a visão, tenho também doença de graves causada pela síndrome. Nessa altura subiram para 67000. Tomo predisolona (lepicortinolo) há dez anos. Em outubro subiram para 3480, subi a dosagem para 20 mg. Agora já desci para 10mg mas voltaram a subir para 960 e rapidamente ultrapassam os 1500.
Está a ser muito difícil de controlar, reduz muito a minha qualidade de vida, provoca-me problemas a vários níveis